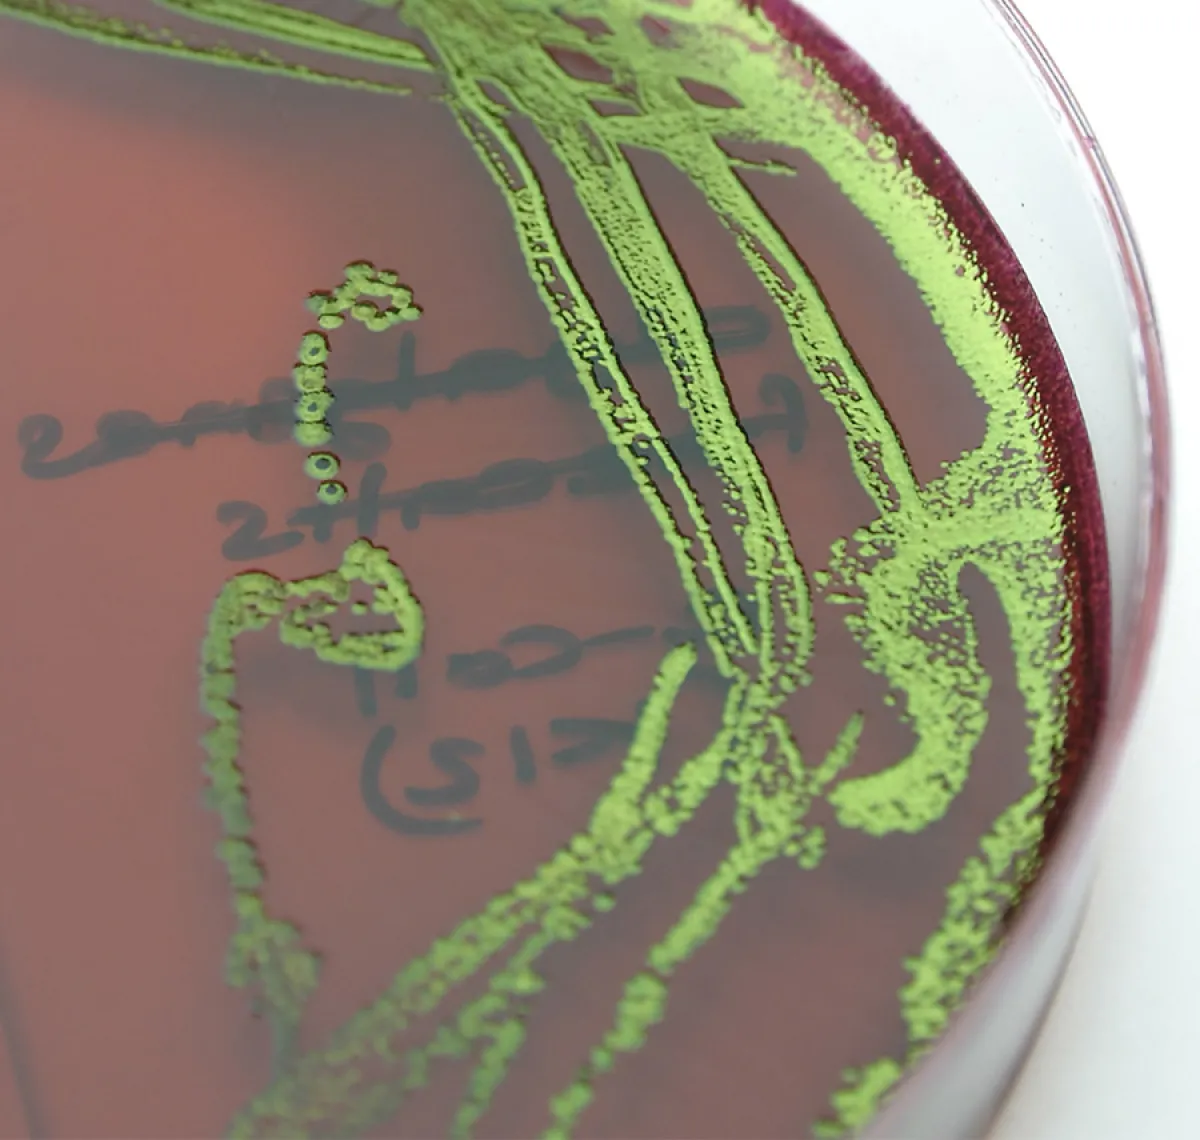

New course for 2014
Publication date
Monday, 14 Oct 2013
Body
Image
An exciting new third year course is offered in Semester 2 2014.
BIOL3193 Bacteria and Health: An Ecological and Evolutionary Perspective. This course will describe how ecological factors play an important role in the health of humans and other animal. It will also look at the animal microbial communities and their role in nutrition, disease prevention and as a cause of disease.
Only 45 places are available and enrolment to this course will be merit based. Please email David Gordon (David.Gordon@anu.edu.au) for permission code to enrol in the course.
